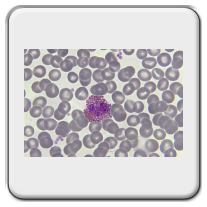

Disclaimer: All images of slides, equipment and videos shown on this website have been produced by the author and are therefore not for free use. You must ask permission for publication in any form at all times.
Bone forming in various histological stains. More information can be found in the sample description.
Nissle substance in motor neurons, cresyl violet acetate staining. More information can be found in the sample description.
Preparation details,
The brain stem and cerebellum were taken from a Guinea pig and fixed in formaldehyde 4%.
The block was embedded in paraplast plus and then cut on an A&O 820 rotary microtome. Thickness is 4µm.
Depex from the company Serva was chosen as mount resin and can be purchased there, see sample discription for more details.